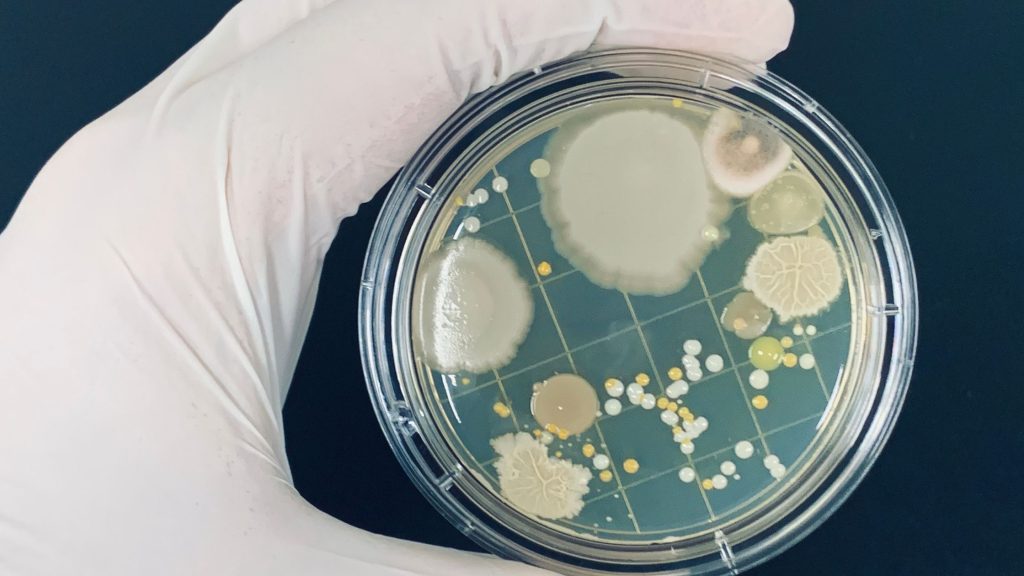
The Benefits of Composting for Soil Health

Composting is a natural process that can help improve soil health and support sustainable agriculture.
By decomposing organic matter, composting creates a nutrient-rich soil amendment that can provide a range of benefits for plants and ecosystems.
In this article, we will explore the benefits of composting for soil health and discuss how you can get started with composting at home.

One of the key benefits of composting is its ability to support nutrient cycling in the soil.
Compost is rich in nitrogen, phosphorus, and other essential nutrients that are necessary for plant growth.
As compost breaks down in the soil, these nutrients are released slowly, providing a long-lasting source of nutrition for plants.
This process also helps to reduce nutrient runoff, which can pollute nearby waterways and harm aquatic ecosystems.

Composting can also support carbon sequestration, which is the process of removing carbon dioxide from the atmosphere and storing it in soil.
When organic matter decomposes in the soil, it releases carbon dioxide into the atmosphere.
However, by composting this organic matter, we can capture and store that carbon in the soil.
This not only helps to mitigate climate change but also supports soil health by improving soil structure and water retention
Composting can also increase microbial activity in the soil.
Microbes play a crucial role in nutrient cycling and soil health, helping to break down organic matter and release nutrients for plant uptake.
Compost is rich in beneficial microbes, including bacteria, fungi, and other microorganisms that can help improve soil fertility and support plant growth.

Composting can also be used as a fertilizer alternative.
Unlike chemical fertilizers, which can harm soil health and pollute nearby waterways, compost is a natural and sustainable source of plant nutrition.
By using compost instead of chemical fertilizers, we can reduce our environmental impact and support sustainable agriculture.

If you’re interested in getting started with composting, there are a few things to keep in mind.
First, you’ll need to choose a composting method that works for your space and lifestyle.
This could include a backyard compost bin, a worm bin, or a compost tumbler.
You’ll also need to collect and compost organic matter, such as food scraps, yard waste, and paper products.
Composting is a simple and effective way to improve soil health and support sustainable agriculture.
By supporting nutrient cycling, carbon sequestration, and increased microbial activity, composting can help create healthy, thriving ecosystems.
By getting started with composting at home, you can play a role in supporting the health of the planet and its inhabitants.